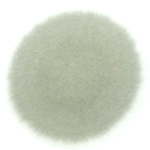

[¿¢¼¾Æ® 1.6VGTµðÁ© 2012] [ºí·Ô½ºÆÌÅ×½ºÆ®½ÃÆ®] ºí·Ô½ºÆÌ Å×½ºÆ®#2
![]() |
Á¤ÀçÈÆ|¹Ð¹ö±×
2013-07-08 09:24 ´ñ±Û:10 ÀÐÀ½:5292 22665Æ÷ÀÎÆ® 17°Ô½Ã±Û 78´ñ±Û ÃßõÇÑ±Û 3 |


| Â÷Á¾¹×³â½Ä | ¿¢¼¾Æ® À§Æ® 1.6 µðÁ© 2013 |
|---|---|
| ¿¬·á | µðÁ© |
| ÃÑÁÖÇà°Å¸® | 2,379 km |
| ¿ÀÀϱ³È¯ÈÄÁÖÇà°Å¸® | 1,548 km |
| ¿ÀÀÏÁ¾·ù | Royal Purple EBI 10w30 |
| ÁÖÇà¿©°Ç | °í¼Óµµ·Î 80% , ½Ã³»ÁÖÇà 20% |
| ½Ã¿ëÈıâ | ½ÅÂ÷ ±¸ÀÔ ÈÄ 831km ¿¡¼ Royal Purple EBI ·Î ÀÚ°¡±³Ã¼ Çß°í¿ä, ÇöÀç ´õ 1,548 Ÿ°í ÃÖÁ¾ÁÖÇà°Å¸®´Â 2,379 km ÀÔ´Ï´Ù. 2ÁÖ¸¸¿¡ 1,500km ÀÌ»ó ´Þ·Á¹ö·È³×¿ä. ¤¾ ¾ÆÁ÷ ½ÅÂ÷ ±æµéÀ̱⠴ܰè¶ó¼ 2~3¹øÁ¤µµ 140km/h ´Þ¸°°Í ¸»°í´Â °ÅÀÇ 100km/h ³»¿Ü ÁÖÇàÇÕ´Ï´Ù. RPM µµ 3,000rpm ¾È ³Ñ±â·Á°í Çϰí¿ä. (Æò½Ã¿¡µµ 2,000 rpm À̳»¿¡¼ º¯¼ÓÇÕ´Ï´Ù.) °ð ³²¾ÆÀÖ´Â EBI 2ÅëÀ» Ãß°¡·Î ±³Ã¼ÇØÁà¾ß µÇ°Ú½À´Ï´Ù. ¤» ¸ðµç ȸ¿ø´Ôµé, ´Ã ¾ÈÀü¿îÇà Çϼ¼¿ä. |
|
·Î¾âÆÛÇÃ|¯^0^
2013-07-08 13:22 1423749P |



|
Á¤ÀçÈÆ|¹Ð¹ö±×
2013-07-08 13:26 22665P |
|
Á¤ÀçÈÆ|¹Ð¹ö±×
2013-07-08 13:29 22665P |
|
·Î¾âÆÛÇÃ|¯^0^
2013-07-08 19:12 1423749P |
|
Á¤ÀçÈÆ|¹Ð¹ö±×
2013-07-09 09:15 22665P |
|
·Î¾âÆÛÇÃ|¯^0^
2013-07-09 18:30 1423749P |

|
Á¤ÀçÈÆ|¹Ð¹ö±×
2013-07-10 09:11 22665P |
|
·Î¾âÆÛÇÃ|¯^0^
2013-07-10 10:03 1423749P |
|
¹éö¹Î|¹é°¡À̹ö
2013-07-10 20:33 401373P |
070-8623-1234
Àϵµ»ê¾÷ÁÖ½Äȸ»ç | ´ëÇ¥ÀÚ : ±è¹Î¾Æ
ºÎ»ê±¤¿ª½Ã µ¿·¡±¸ ¾È¶ô2µ¿ 462-34 2F
»ç¾÷ÀÚµî·Ï¹øÈ£:607-81-84566
Åë½ÅÆÇ¸Å½Å°í¹øÈ£:Á¦2011-ºÎ»êµ¿·¡-0177È£
°³ÀÎÁ¤º¸º¸È£°ü¸®ÀÚ : ±è¹Î¾Æ
makim1010@naver.com
Copyright by ildo industry Co, Ltd.
PC¹öÀü
Á¤Ç°±¸¸Å¾È³»
¸â¹ö½Ê¾È³»